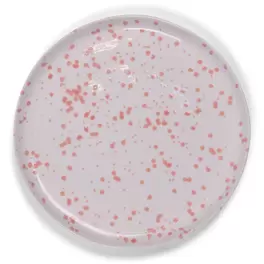
Ontbijtbord Lucie Ø21 cm coral

Deze maand, in april van het jaar 2026, zijn we enthousiast om je de meest aantrekkelijke en concurrerende aanbiedingen voor Nagellak te bieden, beschikbaar in heel Nederland. Bij Tiendeo is ons doel om je toegang te geven tot een breed scala aan producten in de categorie , zodat je precies vindt wat je nodig hebt tegen onverslaanbare prijzen.
We begrijpen hoe belangrijk het is om het maximale uit je aankopen te halen. Daarom hebben we zorgvuldig een selectie van aanbiedingen voor Nagellak samengesteld, zodat je kunt genieten van hoogwaardige producten zonder je budget te overschrijden. Onze selectie omvat een breed scala aan opties om aan al je behoeften en voorkeuren te voldoen, zodat elke aankoop een kans is om te besparen.
Bezoek onze website en ontdek waarom duizenden gebruikers voor ons kiezen, niet alleen om te besparen, maar ook om producten te vinden die hun levenskwaliteit verbeteren. Wat je ook zoekt, wij hebben de beste aanbiedingen en promoties in voor je klaarstaan.
Grijp deze unieke kans om Nagellak tegen onverslaanbare prijzen aan te schaffen. Vergeet niet dat onze aanbiedingen slechts tijdelijk beschikbaar zijn en voortdurend worden bijgewerkt om je de beste producten op de markt te bieden. Mis deze kans niet om Nagellak die je zo graag wilt, voor de beste prijs te krijgen!